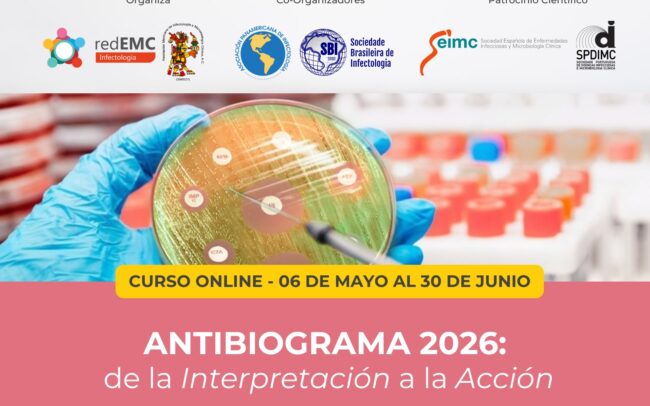

All
Cursos de Infectología
EviMed y la Red de Educación Médica Continua para América Latina redEMC presenta sus cursos 2020 sobre Infectología. Los mismos son dictados de manera 100% online. Esto permite la participación desde cualquier lugar del mundo y en cualquier momento.
Los cursos están dirigidos a infectólogos, especialista en enfermedades infecciosas, microbiólogos, bioquímicos, laboratoristas, farmacéutico clínico, residentes y otros profesionales de la salud interesados en la temática.
La inscripción se realiza a través del formulario de pago de cada curso, donde encontrará también los medios de pago: tarjeta de crédito internacional o paypal, western union, medios de pago local, entre otros.
Para obtener mayor información de los cursos escribir a cursos@evimed.net o ingresar a la página del curso que desea realizar.